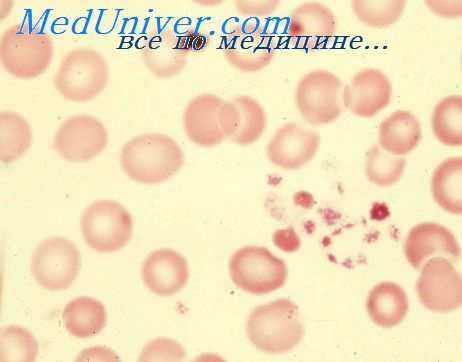
двс-синдром новорожденных

Некротическая флегмона новорожденных. Морфология флегмоны новорожденных
Добавил пользователь Владимир З. Обновлено: 07.01.2026
Синдром диссеминированного внутрисосудистого свертывания (СДВС, тромбогеморрагический синдром) является частым и тяжелым осложнением разноообразных патологических процессов перинатального периода. Он наблюдается при внутриутробной асфиксии и других асфиксических состояниях, шоке, ГБН, пневмопатии новорожденных (синдром гиалиновых мембран, массивные кровоизлияния в легкие), инфекционных заболеваниях, массивных повторных заменных переливаниях крови и др.
Общим для упомянутых процессов является повышение свертывания крови в результате стаза, ацидоза, поступления в сосудистое русло тканевого тромбопластина (например, эритроцитарного тромбопластина при гемолизе, рассасывании гематомы и др.) или микробных токсинов.
Большое значение в развитии ДВС у новорожденных имеет поступление в их организм тромбопластнна плаценты или околоплодных вод (через сосудистую систему или легкие).
На первом этапе ДВС развивается распространенное повышение свертывания крови, главным образом в сосудах микроциркуляторного русла. Образуется большое количество сгустков фибрина, тромбирующих, перекрывающих мелкие сосуды (фибринэмболия). На втором этапе в крови уменьшается количество тромбоцитов, фибриногена, протромбина и других факторов свертывания, расходующихся на образование микротромбов.
Дефицит компонентов свертывания создает коагулопатию потребления и как следствие геморрагический синдром. На третьем этапе СДВС геморрагические явления еще более усиливаются из-за активизации фибрпнолиза в ответ на распространенное повышение свертывания, имевшееся па первом этапе.
Включению этого механизма у новорожденных особенно способствует свойственная им недостаточность ингибиторов плазмина и высокий уровень активаторов плазминогена, что обусловливает высокую активность фибринолиза.
Нарушение свертываемости крови сопровождается гемодинамическими расстройствами, такими как стаз, открытие артерио-венозных шунтов, паралич капилляров и падение артериального давления. Развиваются дистрофические и некротические изменения паренхиматозных органов.
Морфологические изменения при ДВС заключаются в наличии фибриновых тромбов и эмболов в сосудах различных органов, особенно в мелких артериях, венах и капиллярах. Как следствие коагулопатии потребления происходят кровоизлияния в различные органы, кровь в сосудах трупа остается жидкой, трупные свертки крови не образуются. Возможны инфаркты миокарда, некрозы головного мозга или других органов.
Фибрин хорошо выявляется ШИК-реакцией в синусоидах печени, красной пульпы селезенки и надпочечников. Тромбы имеются в сосудах мозга, легких, почек, плаценты, изредка в сосудах желудочно-кишечного тракта, вилочковой железы. Стенки мелких артерий подвергаются мукоидному набуханию, фибриноидному изменению, происходит коагуляционный некроз и десквамация эндотелия. Возможен тромбоз крупных сосудов, например, часто встречается тромбоз синусов твердой мозговой оболочки, тромбоз артериального протока, продолжающийся в аорту, поченых вен.
Врожденные тромбоцитопатии многообразны. Это связано с тем, что тромбоциты содержат значительное количество различных агентов, участвующих во многих этапах гемостаза. В периоде новорожденности могут выявиться следующие редкие врожденные тромбоцитопатии.
